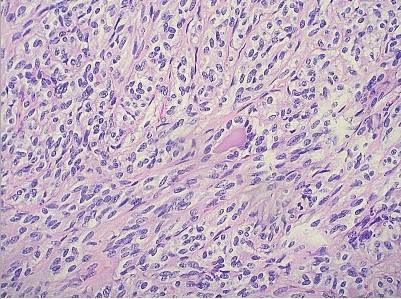
\

SCI论文(www.lunwensci.com):
关键词:肺梭形细胞癌;病例
本文引用格式:杨扬,范惠明,游曼清,等.肺梭形细胞癌1例并文献复习[J].世界最新医学信息文摘,2019,19(92):311.
0引言
肺梭形细胞癌为罕见的肺部恶性肿瘤,其发病率为0.17%-0.4%[1,2],容易误诊误治,国内外报道尚少,现结合文献对近期我院诊断的1例肺梭形细胞癌患者进行报道。
1病例资料
患者男,50岁,以“反复咳嗽半年”于2019年5月11日入院。患者在半年前无明显诱因出现刺激性干咳,伴活动后心累气紧,无发热、畏寒,无咯血及痰血等,患者于当地医院就诊,行胸部CT检查,提示:右肺中间段支气管以远大部分支气管内密度增高影充填,强化不明显。给予抗感染治疗后症状未见明显改善,为求进一步诊治收入我院。自患病以来,患者食欲尚可,睡眠可,大小便未见明显异常,体重有所下降。平素有长期大量吸烟史(吸烟30年,每天约30支)。其余病史无特殊。入院时查体:T 36.6℃,脉搏72次/分,呼吸18次/分,血压141/98mmHg,浅表淋巴结未扪及肿大,右侧呼吸音稍减低,未闻及明显干湿性啰音,腹部及心脏查体未见明显异常。
诊治经过:入院后完善血常规、肝肾功、肿瘤标志物均未见明显异常。浅表淋巴结超声检查未见明显异常长大淋巴结。头颅MRI检查及PET-CT未见明显转移征象。于2019年5月13日行电子支气管镜检查,镜下见右肺中间段支气管菜花样新生物完全阻塞管腔,表面覆盖较多炎性坏死物质,组织松散(见图1)。术后病理检查提示为曲菌病。遂给予伏立康唑200mg口服q12h治疗,后于2019年5月15日,2019年5月17日及2019年5月20日行支气管镜下冷冻活检,病理组织检查均提示为炎性坏死组织,于2019年5月23日行CT引导下经皮肺穿刺检查,提示为慢性炎。于2019年5月27日再次行支气管镜下冷冻活检,术后证实为梭形细胞癌,免疫组化为EMA(-),Vim(+),SMA(+),Desmin(-),CD34(-),CD99(+),Ki67(+)30%。后患者于上级医院行手术治疗,术后病理检查提示为鳞状细胞癌并梭形细胞癌。
2讨论
根据2015年美国国立综合癌症网络(NCCN)对肺部肿瘤的组织学分类,肺梭形细胞癌(spindle cell carcinoma,SCC)是肉瘤样癌的一个亚型,还包括癌肉瘤(Carcinosarcoma)、多形性癌(Pleomorphic carcinoma,PC)、肺母细胞瘤(Pulmonary blastoma)、巨细胞癌(Giant cell carcinoma,GCC)[3]。大多数文献报道,梭形细胞癌好发于男性,年龄多在50-80岁之间,尤其是大量吸烟者,此例患者与文献报道的一致。由于移码突变,导致TP53抑癌基因失活,与肺梭形细胞癌的高度侵袭性密切相关[4,5]。
肺梭形细胞癌的临床表现不具有特异性,与其他肺部恶性肿瘤相似,可表现为咳嗽、咳痰、咯血、痰血,中央型可表现为刺激性干咳、阻塞性肺炎、进行性呼吸困难等,周围型症状隐匿,侵犯胸膜时可引起胸痛不适。此例患者主要表现为刺激性干咳,气道内为中央型肿块[6]。
SCC镜下仅由恶性梭形细胞组成,可粘附呈巢状、漩涡状或不规则束状紧密排列,核分裂相多见,可见肉瘤样生长及局灶性和分散的淋巴浆细胞围绕并浸润肿瘤实质[7]。偶尔可被大量炎性渗出物所覆盖或混合[8],导致其与炎症相混淆,此患者电子支气管镜下可见明显炎性坏死物,经4次电子支气管镜冷冻活检及肺穿刺活检均提示为炎症改变,在第5次支气管镜下冷冻活检时才确诊,可能与此因素有关。
多数文献显示,肺梭形细胞癌患者较一般肺癌更具侵袭性且放化疗效果不佳,预后差,生存期短[9,10]。手术仍然是其首选的治疗手段,对于不可手术的患者来说,化疗方案尚无标准可依,有文献报道,口服三氧化锗可能有一定疗效[10]。
参考文献
[1]Rossi G,Cavazza A,Sturm N,et al.Pulmonary carcinomas with pleomorphic,sarcomatoid,or sarcomatous elements:a clinicopathologic and immunohistochemical study of 75 cases[J].Am J Surg Pathol,2003,27(3):311-324.
[2]Terada T.Spindle cell carcinoma of the lung:Frequency,clinical features,and immunohistochemical studies of three cases[J].Respiratory Medicine CME,2010,3(4):241-245.
[3]Ettinger DS,Wood DE,Akerley W,et al.Non-Small Cell Lung Cancer[J].J Natl Compr Canc Netw,2015,13(5):515-524.
[4]Kontic M,Stojsic J,Stevic R,et al.Could spindle cell lung carcinoma be considered and treated as sarcoma,according to its clinical course,morphology,immunophenotype and genetic finding?[J].Pathol Oncol Res,2013,19(1):129-133.
[5]Mainwaring MG,Poor C,Zander DS,et al.Complete remission of pulmonary spindle cell carcinoma after treatment with oral germanium sesquioxide[J].Chest,2000,117(2):591-593.
[6]Carter BW 1,Benveniste MF 1,Betancourt SL.Imaging Evaluation of Malignant Chest Wall Neoplasms[J].Radiographics,2016,36(5):1285-306.
[7]李向南,胡建明.肺梭状细胞癌1例并文献复习[J].临床肺科杂志,2017,22(08):1550-1551.
[8]Travis WD,Brambilla E,Müller-Hermelink HK,et al.Pathology and genetics of tumours of the lung,pleura,thymus and heart[M].Lyon:IARCPress,2004.55-59.
[9]段楚骁,付圣灵,付向宁.肺梭形细胞癌4例分析[J].实用医学杂志,2014,30(24):4060-4061.
[10]Chang YL 1,Lee YC,Shih JY,et al.Pulmonary pleomorphic(spindle)cell carcinoma:peculiar clinicopathologic manifestations different from ordinary non-small cell carcinoma[J].Lung Cancer,2001,34(1):91-97.
关注SCI论文创作发表,寻求SCI论文修改润色、SCI论文代发表等服务支撑,请锁定SCI论文网! 文章出自SCI论文网转载请注明出处:https://www.lunwensci.com/yixuelunwen/23558.html